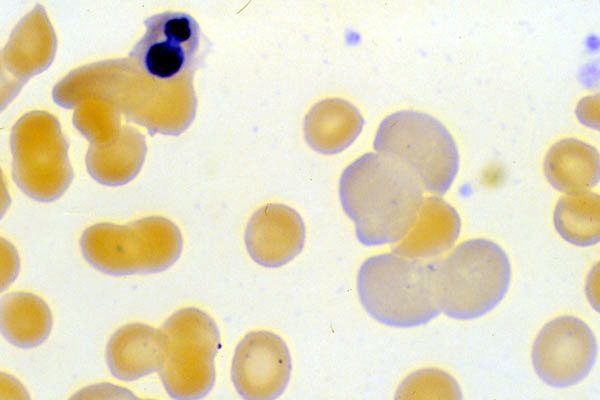

Nucleated RBC and polychromasia, hemolytic anemia, peripheral blood smear
Click picture to enlarge. Close window to return
The patient has undergone an episode of hemolysis. There is evidence of appropriate bone marrow response as nucleated RBC's and polychromasia are present. You would expect an increased reticulocyte count.